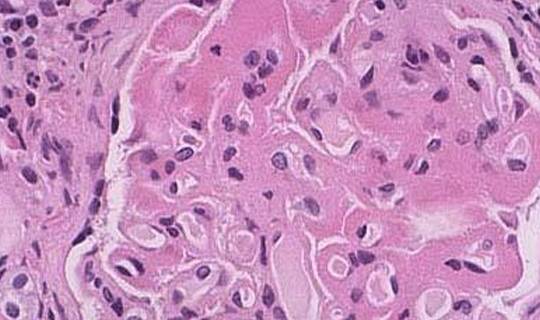
症状|狼疮性肾炎是什么？有什么症状？看了您就懂了！

症状|狼疮性肾炎是什么?有什么症状?看了您就懂了!
【症状|狼疮性肾炎是什么?有什么症状?看了您就懂了!】我们知道 , 慢性肾脏病不是一个具体的病 , 而是涵盖了肾小球疾病、肾小管间质性疾病、肾血管性疾病以及遗传性肾脏疾病等几十个具体肾病及其他各种原因引起的慢性肾脏结构和功能障碍 。
前面小编给大家分别介绍了IgA肾病、糖尿病肾病及腹透和血透的相关知识 , 今天咱们就来开始另一个专题 , 看看最常见的继发性肾小球疾病之一——狼疮性肾炎 。

文章图片
系统性红斑狼疮是一种公认的自身免疫性疾病 , 其女性发病率要远大于男性 , 男女之比约为1∶8~1∶9 。
红斑狼疮的病变大多累及数个系统或器官 , 如累及到皮肤 , 患者会出现面部的蝶形红斑;累及到关节 , 患者会出现关节痛;当累及到肾脏时 , 肾脏受到损害 , 就会导致狼疮性肾炎 。 所以一般来说 , 狼疮性肾炎都是先有狼疮 , 再有肾炎 。
红斑狼疮并发肾炎的几率很高 , 约50%~70%的患者都会出现狼疮性肾炎的临床症状 , 因此红斑狼疮患者应尤其重视肾功能的检查 , 最好每年去医院进行尿检、血检 , 以了解肾功能是否出现损害 。

文章图片
狼疮性肾炎的部分临床表现与一般肾炎无异 , 包括蛋白尿、血尿、水肿、高血压及肾功能不全等 , 肾功能测定早期正常 , 逐渐进展 , 后期可出现尿毒症 。
除此之外 , 狼疮性肾炎还可表现为发热、面部红斑、多形性皮疹、光过敏、多发性口腔溃疡、关节炎、多发性浆膜炎、血管炎及中枢神经系统症状等 。
世界卫生组织将狼疮性肾炎分为6型 , 分别为Ⅰ型正常或微小病变型;Ⅱ型系膜增殖型;Ⅲ型局灶增殖型;Ⅳ型弥漫增殖型;Ⅴ型膜型;Ⅵ型硬化型 。
文章图片
由于不同病理类型的狼疮性肾炎 , 免疫损伤性质不同 , 治疗方案也有所不同 , 所以大多建议狼疮性肾炎患者行肾脏穿刺活检术 , 以明确病因类型来帮助医生制定针对性的治疗方案 。
- 按摩|你知道吗?间充质干细胞可以改善失眠症状
- 救治|广东珠海:奥密克戎感染后症状相对较轻 新增病例年轻人偏多
- 德尔塔|珠海:奥密克戎感染后症状相对较轻,新增病例年轻人偏多
- 德尔塔|广东珠海:奥密克戎感染后症状相对较轻 新增病例年轻人偏多
- 建议|身体即将透支的几个警报 你有这些症状吗
- 报告|珠海累计确诊病例12例、无症状感染者1例
- 饮食|患有慢性肾炎,饮食要牢记这4点,以免增加肾脏负担,需了解
- 肝病医院|贵州盛京中医肝病医院:有这些症状要警惕是肝腹水
- 非法|湖南16日新增境外输入无症状感染者1例
- 隔离|广州新增境外输入确诊病例5例、境外输入无症状感染者2例
